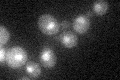
YOR304W
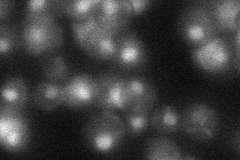
YOR304W
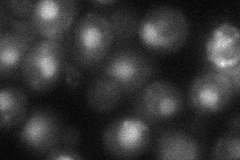
YOR304W

View description
ATP-dependent DNA translocase involved in chromatin remodeling; ATPase component that, with Itc1p, forms a complex required for repression of a-specific genes, INO1, and early meiotic genes during mitotic growth
Localization:
Intensity:
Fold change:
Significance:
-
C’ GFP library in SD
nucleus19.41 -
N' NOP1pr-GFP in SD

nucleus0 -
N' TEF2pr-mCherry in SD

nucleus51.1418 -
N' NATIVEpr-GFP in SD
nucleus27.9278 -
N' TEF2pr-VC and Cyto-VN in SD
nucleus37.2539 -
C’ GFP library in SD+DTT

nucleus15.420.79No -
C’ GFP library in SD+H2O2

nucleus20.761.06No -
C’ GFP library in Starvation Media

nucleus18.250.93No -
C’ GFP library on the background of Pup2-DaMP

nucleus -
C’ GFP library on the background of CCT mutant

nucleus17.24920.888177No
